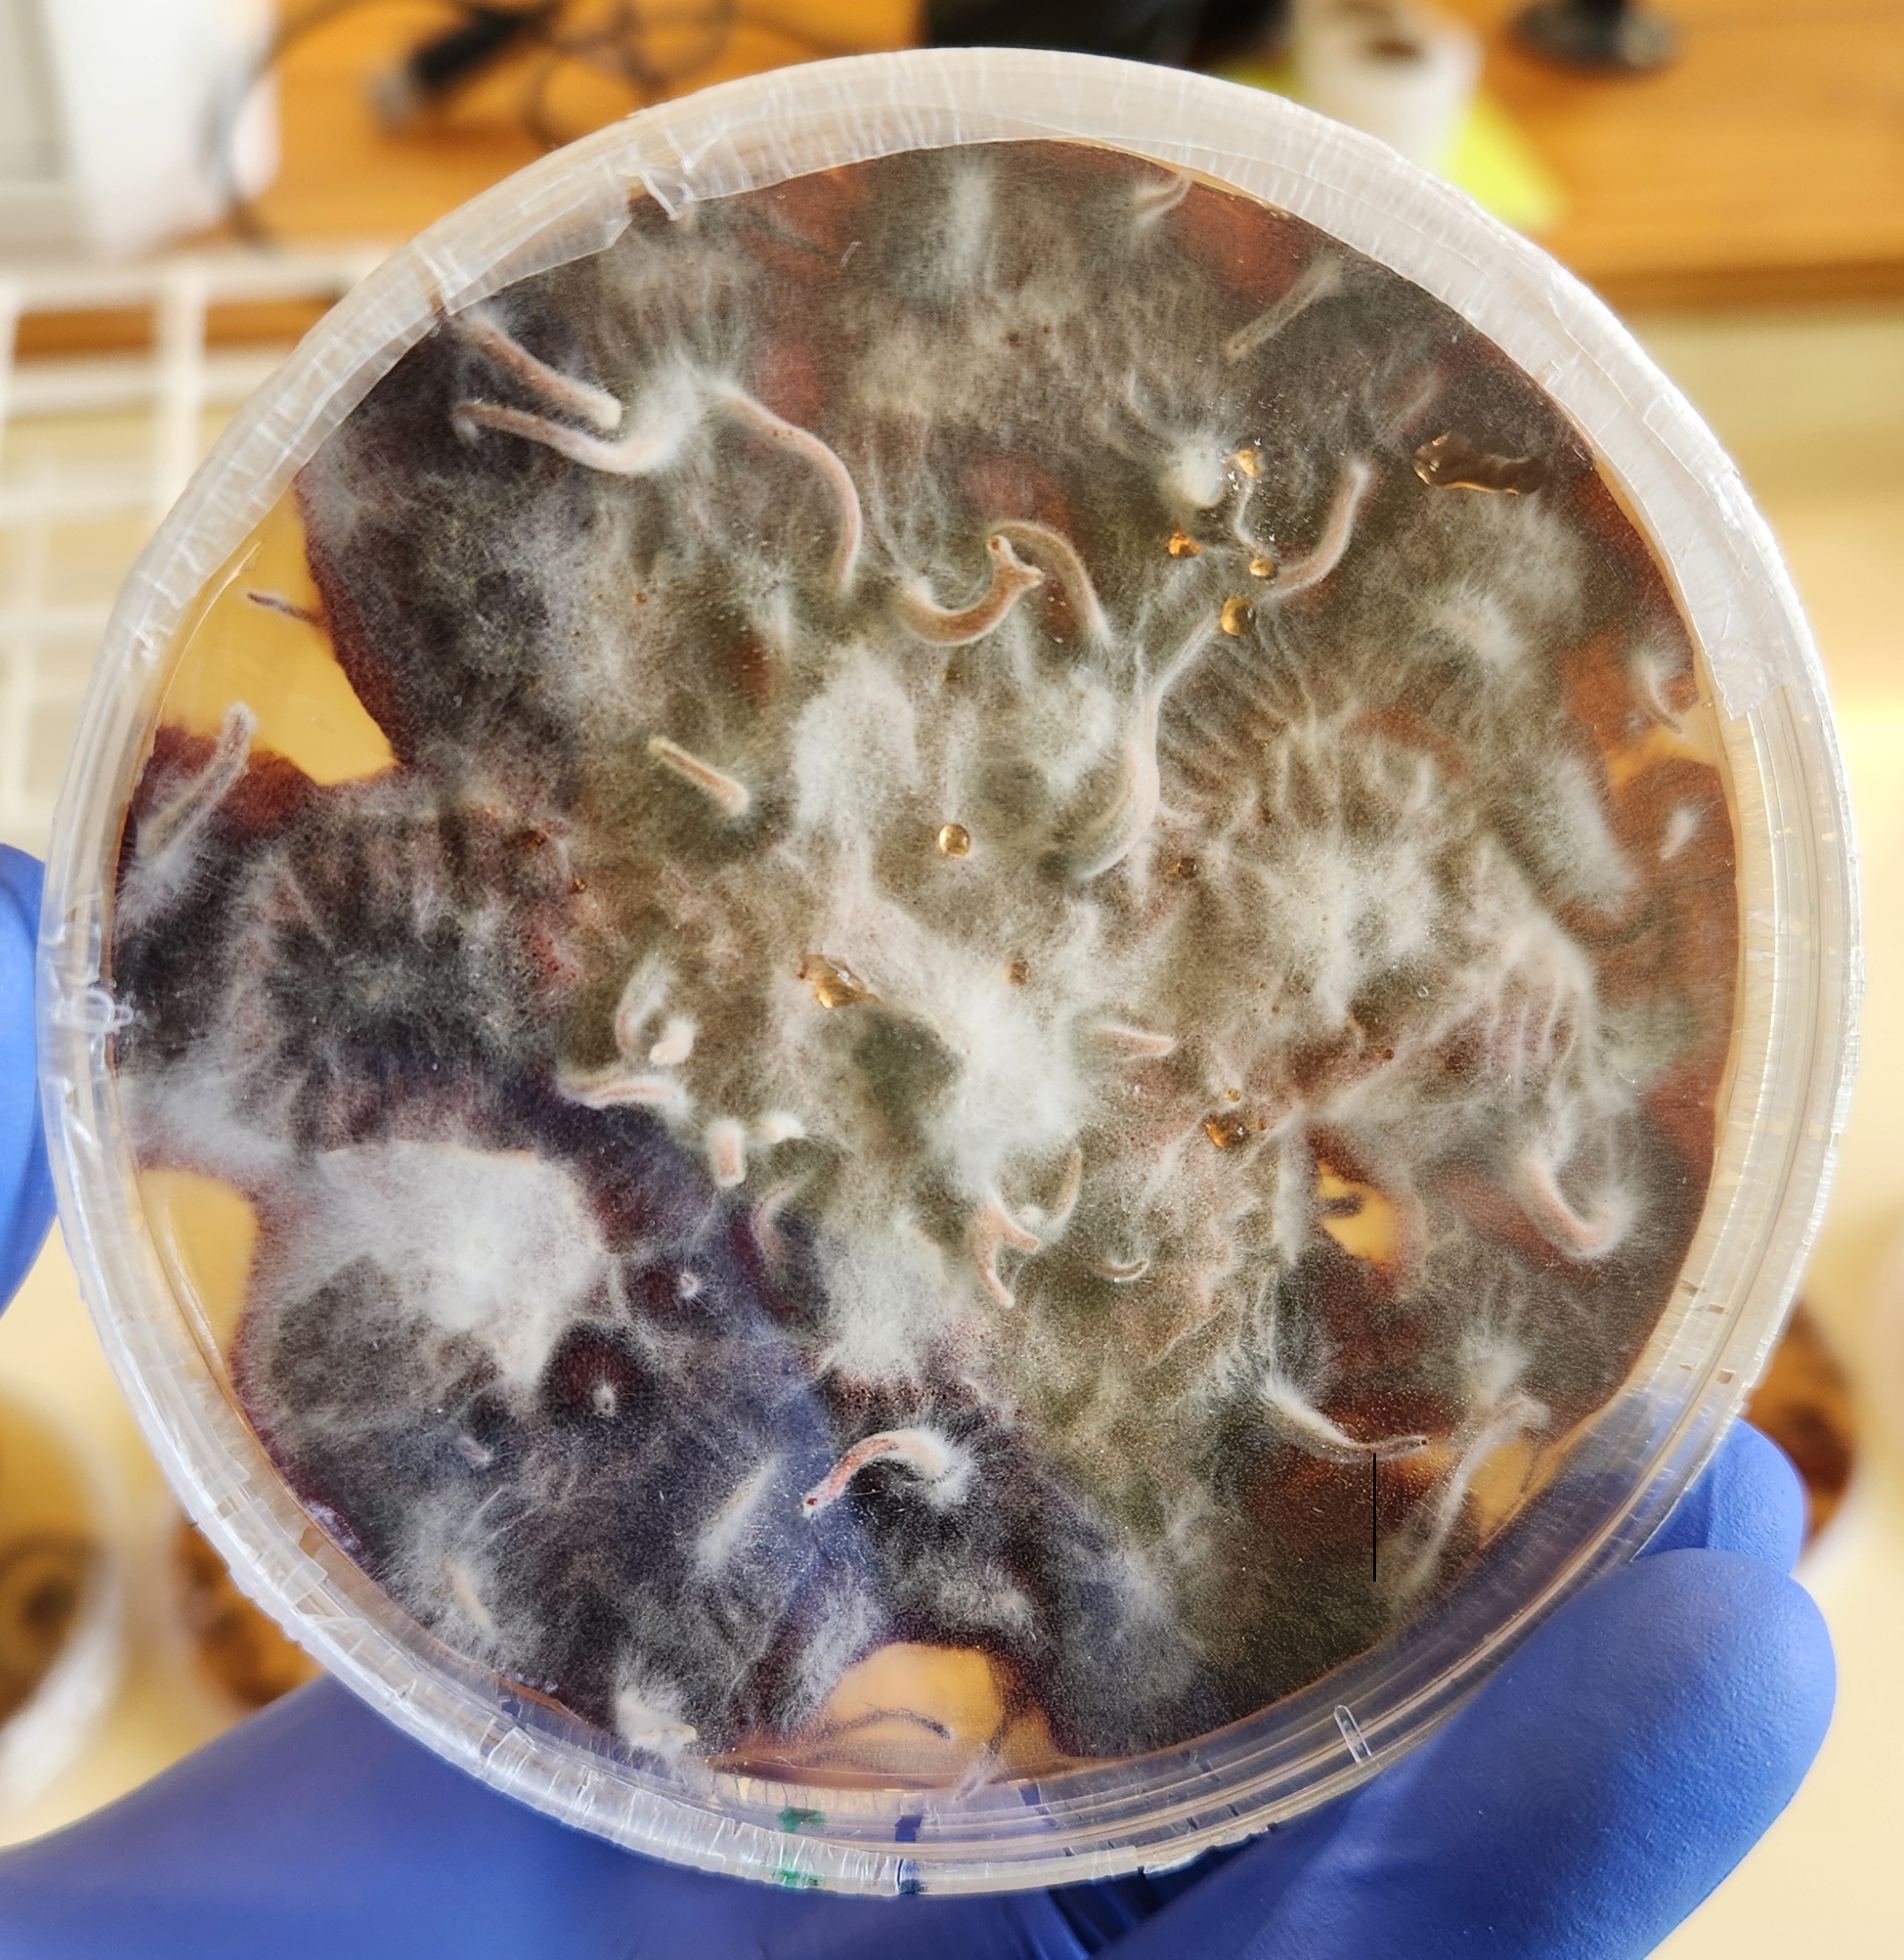

Welcome to the first issue of Forest Health News under the Bioeconomy Science Institute.
In this edition, we highlight stories that show the value of collaboration across our science teams. You’ll find updates from a recent site visit by the Forest Health Reference Laboratory, insights into how science societies shape research impact, and a research feature on red needle cast and its effects on radiata pine.
We invite you to explore these stories as we continue working to strengthen forest health and resilience.
Testing the Toolbox: making biocontrol agents safer for the environment
Andrew Pugh and Jacqui Todd
Biological control is an effective and environmentally friendly way to manage insects, pathogens, and weeds. Classical biological control (biocontrol) is the practice by which a beneficial natural enemy is introduced from the pest’s home range, for example ladybugs to eat aphids. This method has a strong track record of effectiveness both in New Zealand and around the world. Prior to the introduction of a new biocontrol agent (BCA), a careful risk assessment must be undertaken to ensure it won’t cause unintended harm to non-target organisms, particularly those beneficial or native insects such as bees or huhu.
New Zealand is a world leader in the risk assessment process for the introduction of beneficial BCAs. Any introduced BCAs go through an intensive suite of testing to minimise any chance of negative impacts before they are assessed and approved by the Environmental Protection Authority.
“Testing the Toolbox” was a three-year Better Border Biosecurity (B3) collaboration between Plant & Food Research, AgResearch, Manaaki Whenua Landcare Research, and Scion, now all part of the Bioeconomy Science Institute. To ‘test the toolbox’ several predictive tools were used to identify potential non-target impacts from a range of BCAs. These included include a food web visualisation tool, a Bayesian probability network tool (the Biocontrol Adverse Impact Probability Assessment [BAIPA] tool developed at Scion), a Machine Learning Tool, pre-release quarantine tests, and assessments of host-use stability over time. The tools were field tested across a range of case studies focussed on BCAs for three pests (leafrollers, pasture and lucerne weevils, codling moth) and two weeds (old man’s beard, St. John’s wort).
The data gave useful insights about biocontrol risk assessment for both researchers and regulators. Food web visualisation made it easier to understand the impact BCAs would have on the environment after release, informing pre-release testing of proposed new BCAs. Research on old man’s beard highlighted how the associated insect community has shifted since the mid-2000s, underscoring the difficulty of accurately predicting community impacts from new BCA introductions.
The value of the BAIPA tool was validated by providing useful insights into the degree of non-target impact for BCAs. BAIPA predicted the low likelihood of the codling moth biocontrol agent Mastrus ridens interacting with non-target hosts.
Not all tools are fit for purpose. The machine learning model, which used a random forest approach, proved unreliable in predicting hosts. This was likely due to the limited trait data available, especially when traits were only recorded at the family or genus level rather than for individual species. Further refinement and testing of this tool are needed before it can be applied with confidence.
When assessing the impact of three introduced Microctonus spp. BCAs for pest weevils in pasture and lucerne on non-target hosts, we found that pre-release laboratory testing gives a good indication of post-release impacts. These impacts may change over time, particularly as more Microctonus are introduced (either intentionally or otherwise).
Few studies track the effects of BCAs after they are released into new ecosystems. This project provided a rare opportunity to study ecological interactions between BCAs and New Zealand’s native plants and animals across a wide range of habitats, creating a valuable resource for researchers and regulators. The knowledge gained will help ensure that future BCA introductions are safer than ever.

Case studies in this project allowed the team to collect focal species from a range of ecosystems, including abandoned apple orchards and areas of native forest being strangled by old man’s beard, Clematis vitalba.
Cross-collaboration strengthens diagnostic capacity
Renelle O’Neill
The recent formation of the Bioeconomy Science Institute has created new opportunities for collaboration and shared expertise. One of the first formal cross-Bioeconomy Science Institute diagnostics projects is underway, bringing researchers together from Plant and Food Research group and Scion group. The aim of the project is to use molecular methods to identify pathogens from horticultural soils.
As part of a Bioeconomy Science Institute Kiwifruit Royalty Investment Programme, Kaiawhina Rangahau (Research Associate) Teiarere Stephens from the Te Puke site, visited Scion’s Rotorua campus for hands-on training in molecular diagnostics. This work included DNA extraction from fungal cultures, PCR amplification, and sequencing of a barcoding gene to confirm the identity of soil pathogens. Alongside these routine diagnostic methods, the project trialled a novel UP-PCR (Universally Primed PCR) technique. UP-PCR generates species-specific DNA fingerprinting patterns, providing an additional comparative tool for pathogen identification. These methods allowed for successful identification of fungal isolates such as Armillaria novae-zealandiae.
The training not only ensured successful identification of the fungal cultures but also built capability across institutes in applying molecular diagnostic tools. In strengthening cross-Bioeconomy Science Institute partnerships, sharing facilities, expertise, and methods, research groups are enhancing New Zealand’s national capacity in molecular diagnostics for plant health. The project highlights the value of joint initiatives and sets the stage for future collaborations that support biosecurity.
Paeroa’s lone pines leave the battlefield
Darryl Herron
On the Paeroa Golf Course, two Turkish red pines (Pinus brutia) were planted as living memorials. These trees trace their lineage back to the original Lone Pine of the Gallipoli campaign in World War I.
After the battle, Sergeant Keith McDowell collected cones from the Lone pine in Gallipoli and brought the seed home to Australia and New Zealand. From these, trees were raised and shared as symbols of remembrance. One of those seeds grew into the Lone Pine at Paeroa Golf Course, planted in 1948. In 2015, seed from this tree was provided to Scion (now part of the Bioeconomy Science Institute), which propagated seedlings and donated them to RSAs and other organisations for the ANZAC centenary.
In recent years, the original 1948 tree died. Its successor, planted only a few metres away, has now also begun to decline. Members of Scion group’s Forest Health Reference Laboratory visited the site to investigate the cause.
Their field and lab assessments confirmed the tree is stressed, likely suffering from “wet feet” that is the result of prolonged root submersion in a high water table. No signs of a pathogen were found.
To preserve its legacy, cones were collected from the tree. Seedlings will be raised from this seed and gifted back to the golf course, with the intention of planting them in better-drained areas where they can thrive.
Although the original pines at Paeroa have fallen, their story continues through the next generation of seedlings — living reminders of sacrifice, remembrance, and resilience.
The importance of science societies in New Zealand
Darryl Herron
New Zealand Plant Protection Society (NZPPS) 78th annual meeting
The New Zealand Plant Protection Society (NZPPS) held its 78th annual meeting in August, hosting more than 150 researchers from New Zealand, Australia, the Pacific, and further abroad. Over three days, 72 talks and 18 posters were presented, along with a dedicated research symposium on the issue of pesticide resistance co-hosted with A Lighter Touch that drew 130 attendees.
Two influential researchers were honoured at the meeting for their contributions to the Society and to science in Aotearoa New Zealand. Emeritus scientist and entomologist Dr Stephen Goldson (AgResearch) received the NZPPS medal. Over several decades, he has played a central role in protecting New Zealand’s agriculture sector from pests and diseases, served as Director of Better Border Biosecurity (B3), and acted as a strategic advisor to the former Prime Minister’s Chief Science Advisor, Sir Professor Peter Gluckman. Principal scientist Dr David Teulon (Plant & Food Research), also a former Director of B3, was awarded life membership of the Society in recognition of his outstanding contribution to plant protection in New Zealand and across the Pacific.
The society’s roots go back to 1948, when the first “National Weeds Conference” was held at Lincoln Agricultural College. At the time, chemical management of weeds and pests was transforming farming. Since then, NZPPS has broadened its scope to include biocontrol, pathogens, insect pests, and forest health—critical issues that cut across all of New Zealand’s primary sectors.
Today, NZPPS brings together scientists, industry, growers, foresters, iwi, and government to advance knowledge and practice in plant protection. Its work spans the biosecurity continuum—from assessing pre-border risks to managing pests and diseases across agriculture, horticulture, forestry, and natural ecosystems. Through its annual conference, international links, and scientific journal, the Society provides a trusted forum for sharing research, strengthening collaboration, and supporting education.
This year’s meeting coincided with the start of New Zealand’s science sector reform. From July 2025, researchers from AgResearch, Plant & Food Research, Manaaki Whenua Landcare Research, and Scion will all be part of the new Bioeconomy Science Institute. Understandably, there was lively discussion about what this reform means for researchers, industry, and the Society itself. Dame Professor Alison Stewart’s opening address set the tone, challenging members to consider the role of NZPPS in this new era. The incoming president, early-career researcher Dr Thomas (Tom) Carlin from the Bioeconomy Science Institute, will now lead this conversation and strengthen the Society’s role by creating new opportunities for members to engage, expanding its digital reach, and building stronger links with other societies.
As we navigate reform, one message is clear: societies like NZPPS matter more than ever. They bridge science, industry, and practice. They hold collective knowledge, nurture future scientists, and provide trusted spaces for collaboration. They connect New Zealand’s science to the Pacific and the world, while staying grounded in local needs.
For forestry, agriculture, horticulture, and beyond, these societies are a source of continuity and strength in uncertain times. They remind us that science is not just about institutions—it is about people, networks, and shared purpose. In a period of change, that may well be our strongest foundation.
Finds from the Forest Health Reference Lab
Kiryn Dobbie
Dieback — the gradual decline and death of shoots, branches, or even whole trees — is a common problem we see in the Forest Health Reference Laboratory. When dieback is spotted on trees in the cypress family (Cupressaceae), the usual suspect is Cypress canker caused by Seiridium species.
A recent sample told a different story. As part of the Forest Biosecurity Surveillance programme, a Thuja occidentalis (northern white-cedar) showing needle dieback was collected. There were no obvious signs of cankers, but closer examination revealed the fungus Pseudocercospora thujina (previously Stigmina thujina) fruiting prolifically on the dead portions of the needles. Symptoms of needle cast in the lower crown described by the surveyor (BiotaSPS, Ben Doherty), noted needle browning in the lower crown — a classic symptom of this pathogen.
The fungus isn’t new to New Zealand. Records in the Forest Health Database, which holds more than 250,000 forest health observations dating back to 1974, show that Pseudocercosporathujinais widespread, particularly on Chamaecyparis and Thuja species. Repeated infections on Lawson’s cypress (C. lawsoniana)on the West Coast of the South Island have killed trees in the region. It s not a serious pathogen elsewhere in New Zealand (Gadgil, 2005).
While this particular pathogen is established here, it’s important to keep watching closely. There are many other serious diseases of cypress overseas that we do not want in New Zealand. Careful sampling and diagnostics are essential to protect our urban plantation forests from new threats.
GADGIL, P. D. 2005. Fungi on trees and shrubs in New Zealand. (No Title).
Virus supercharges red needle cast: implications for radiata pine health
Dr Rebecca McDougal (Bioeconomy Science Institute - Scion Group), Dr Nicole (Zhi) Xu (Bioeconomy Science Institute - Plant and Food Research Group, University of Auckland)* and Dr Grant Smith (Bioeconomy Science Institute - Plant and Food Research Group)
Figure 6. An example of red needle cast symptoms on detached pine needles. A pine need fascicle was inoculated with 4018_V (A,B) and 4018_C (C,D), respectively. Olive or khaki regions (A,C) with resinous dark marks (B) developed on needles. Hyphae were also observed from the symptomatic regions under a stereo microscope (B). Needles were photographed 5 days post inoculation. An example of an uninoculated healthy pine needle E, F.
Phytophthora pluvialis, the microscopic organism behind red needle cast (RNC) in radiata pine, has become a serious concern for forest health in Aotearoa New Zealand. This pathogen (originally found in Pacific Northwest USA) is now well-established in NZ pine plantations, where it causes widespread needle loss and economic damage. Recent research accepted for publication in the peer-reviewed journal Plant Disease (and available as a ‘first view’ here) has uncovered a surprising new dimension to this story: the presence of a novel RNA virus, Phytophthora pluvialis RNA virus 1 (PpRV1), which seems to make the pathogen even more aggressive.
This study compared PpRV1-infected and PpRV1-free isolates of P. pluvialis to see how the virus affected the pathogen’s appearance, growth, and ability to infect pine needles. Phytophthora pluvialis isolates were sourced from New Zealand, including isolates that contained the virus and variants which had been “cured” of the virus via chemical treatments as part of the study.
Virus-infected P. pluvialis colonies were slightly larger and produced more spores and infective structures (aerial hyphae, sporangia, hyphal swelling) than their virus-free counterparts. One of the Phytophthora PplRV1b-infected isolates produced 10-fold more zoospores (primary infection spores) than its virus-free variant, and caused more severe RNC symptoms on pine. Accelerated growth alongside heightened virulence suggests a complex and potentially novel interaction between the virus and its host.
Researchers also examined the ability of the PpRV1 virus to spread between different P. pluvialis isolates. They observed the virus being passed down to offspring of infected isolates, but did not see the virus infecting virus-free isolates. This suggests that PpRV1 distribution may be limited to specific P. pluvialis lineages rather than widespread across populations.
These findings challenge conventional understandings of virus-host interactions. Many viruses are known to reduce pathogenicity of their host (hypovirulence), but the PpRV1 virus appears to enhance the aggressiveness of P. pluvialis (hypervirulence). This is the first documented case of a virus inducing hypervirulence in an oomycete forest pathogen. Why this virus makes P. pluvialis more virulent is still a mystery. Researchers are keen to continue this work to understand the distribution of the virus in Aotearoa New Zealand and how PpRV1 interacts with its host.
Hypervirulent P. pluvialis strains pose a serious threat to forest health and productivity in radiata pine plantations, particularly in Aotearoa New Zealand where the radiata is a cornerstone of forestry industry. Monitoring for viral infection in P. pluvialis populations could become an important component of disease management strategies.
Looking beyond the scope of forest pathology and biosecurity, this study shifts our broader understanding of host-pathogen-virus interactions. It opens new avenues for research into the role of viruses in modifying the biology and pathogenicity of Phytophthora species and other oomycetes. Understanding how viruses interact with forest pathogens—particularly when they reduce the pathogenicity of disease-causing organisms—could help turn viruses into biocontrol agents to limit disease severity.
This research was conducted as part of Nicole (Zhi) Xu’s PhD, and Nicole is currently based at Lincoln University working on plant-microbe interactions.
Citation: Z. Xu., F. Kalamorz, R. A. Frampton, R. L. McDougal, R. M. MacDiarmid and G. R. Smith (2025). Phytophthora pluvialis hosting Phytophthora pluvialis RNA virus 1 shows morphological changes and hypervirulence to Pinus radiata needles. Plant Disease 0(ja): null. doi: 10.1094/pdis-05-25-1022-re.
Upcoming Event
The Remote Sensing Cluster Group Meeting will meet on Monday, 17 November, from 1–5 pm in the Totara Room at the Rydges Hotel, Rotorua.
This meeting will take place ahead of ForestTECH 2025 and is on the agenda as a preconference event. For further details, email Michael Watt and view the agenda here.
Sign-up to stay in the loop: RNC Infection Risk Tool
Our prototype RNC infection risk tool enables foresters to gauge the risk of RNC outbreaks and plan interventions. We are seeking expressions of interest to participate in focus groups or from potential partners to help guide development and ensure long-term support.
Sign up or get in touch with Stuart Fraser for more information.